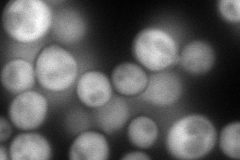
YLR178C
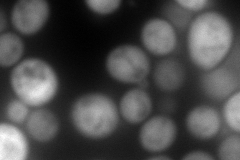
YLR178C
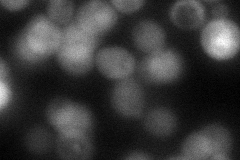
YLR178C
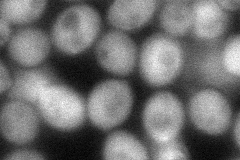
YLR178C
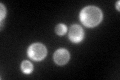
YLR178C

View description
Protein that interacts with and inhibits carboxypeptidase Y and Ira2p; phosphatidylethanolamine-binding protein (PEBP) family member; targets to vacuolar membranes during stationary phase; acetylated by NatB N-terminal acetyltransferase
Localization:
Intensity:
Fold change:
Significance:
-
C’ GFP library in SD

cytosol28.69 -
N' NOP1pr-GFP in SD
cytosol182.616 -
N' TEF2pr-mCherry in SD
cytosol312.385 -
N' NATIVEpr-GFP in SD
cytosol50.7943 -
N' TEF2pr-VC and Cyto-VN in SD
cytosol72.0956 -
C’ GFP library in SD+DTT

cytosol37.961.32No -
C’ GFP library in SD+H2O2

cytosol24.680.86No -
C’ GFP library in Starvation Media
cytosol153.715.35Yes -
C’ GFP library on the background of Pup2-DaMP

cytosol -
C’ GFP library on the background of CCT mutant

cytosol37.40651.30334No
